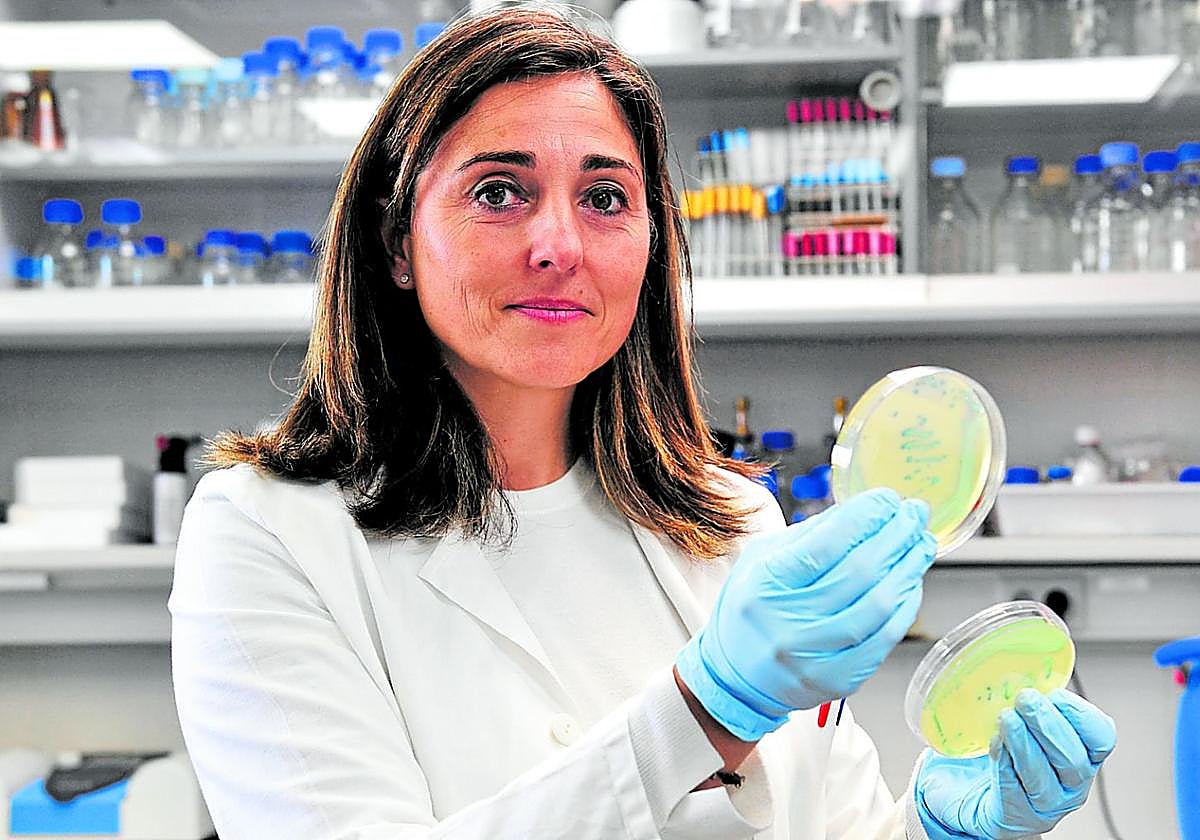
La doctora Ana Allende, del Cebas-CSIC, con unas muestras en el laboratorio.

Cómo acabar con los minienemigos cada vez más fuertes de las hortalizas
Un proyecto financiado por la Fundación Séneca, dependiente del Gobierno regional, busca poner freno a la mayor resistencia a los tratamientos de microorganismos dañinos para los cultivos
Ginés S. Forte
Sábado, 8 de noviembre 2025, 08:32
El campo también se enfrenta a grandes desafíos provocados por minúsculos enemigos. Los microorganismos (bacterias, virus, hongos, parásitos), que en muchos casos resultan beneficiosos para el correcto desarrollo de los cultivos, son también fuente habitual de problemas que los productores conocen bien. Sin embargo, los tratamientos convencionales resultan cada vez menos efectivos. Estos pequeños adversarios (particularmente las bacterias), estimulados por fenómenos provocados por el cambio climático y determinadas prácticas agrícolas, resultan cada vez más duros de tratar.
La investigadora Ana Allende, del Centro de Edafología y Biología del Segura (Cebas-CSIC), encabeza un proyecto centrado en estudiarlo y «diseñar estrategias para reducir su impacto». El trabajo, precisa, «aborda la transmisión de bacterias resistentes y genes de resistencia a antibióticos desde el agua», tanto la de riego como la empleada durante el procesado de frutas y hortalizas, «hacia los productos hortícolas». Y lo hace «considerando el efecto de eventos climáticos extremos como sequías o lluvias torrenciales, cada vez más frecuentes en la Región de Murcia».
A partir de datos experimentales y de la literatura científica, los especialistas implicados en la iniciativa, que arrancó el pasado febrero y se alargará cuatro años, desarrollarán modelos predictivos basados en inteligencia artificial «para anticipar los riesgos y evaluar distintas medidas de mitigación».
Los resultados del proyecto, denominado Agrocare (en inglés 'agro care' significa cuidado agrícola), «proporcionarán evidencias científicas que ayuden en los procesos de toma de decisiones», tanto por parte de los agricultores, como de la industria hortofrutícola y las autoridades competentes «sobre la relación que existe entre el uso del agua en la agricultura y la seguridad alimentaria de los productos comercializados».
Las claves
-
Microorganismos. Bacterias, virus, hongos y parásitos pueden dañar a los cultivos de hortalizas
-
Empoderados. Los fenómenos aparejados al cambio climático y determinadas prácticas agrícolas están favoreciendo la aparición de microorganismos más evolucionados
-
Inteligencia científica y artificial. El proyecto, que se sirve, entre otros recursos, de la inteligencia artificial, busca anticipar los riesgos y evaluar distintas medidas de mitigación
En la práctica, añade la investigadora principal de este trabajo financiado por la Fundación Séneca (Consejería de Medio Ambiente, Universidades, Investigación y Mar Menor), el proyecto busca proporcionar herramientas de predicción y gestión para tres finalidades distintas. La primera trata de evaluar el riesgo de contaminación por bacterias resistentes en función del tipo de agua y de las condiciones climáticas. La segunda pretende identificar estrategias de mitigación más eficaces, como tecnologías de desinfección sostenibles o prácticas agrícolas seguras. Y la tercera se centra en contribuir a una producción hortícola más sostenible y resiliente, «en línea con el Pacto Verde Europeo y los Objetivos de Desarrollo Sostenible».
El objetivo principal en el que se concentra el proyecto se enfoca en «entender cómo el cambio climático y las prácticas agrícolas influyen en la propagación de resistencias antimicrobianas en los sistemas hortícolas», para combatir mejor los microorganismos dañinos (de ahí el término antimicrobiano).
Para lograrlo, la doctora por la Universidad Politécnica de Cartagena (UPCT) en Ciencia y Tecnología de Alimentos, dirige un equipo interdisciplinar en el que se combinan «conocimientos en microbiología, seguridad alimentaria, modelización predictiva y agricultura sostenible». Además de dos doctoras y un doctor del Cebas-CSIC, también hacen «viable» el estudio especialistas de la Escuela Técnica Superior de Ingeniería Agronómica de la UPCT. El trabajo de todos ellos permitirá, durante el periodo del proyecto, desarrollar experimentos en campo y en una planta piloto, la recopilación de datos microbiológicos y ambientales y la elaboración de modelos predictivos que integren las prácticas agrícolas, las condiciones climáticas y los riesgos asociados a la resistencia a los antimicrobianos.

Una misma salud
La especialista en seguridad alimentaria Ana Allende reseña cómo en los últimos años, muchos de los esfuerzos del grupo de Microbiología y Calidad de Frutas y Hortalizas del Cebas-CSIC en el que trabaja «se han centrado en comprender cómo el medio ambiente, especialmente el agua, puede actuar como vector en la diseminación de resistencias antimicrobianas». Para Allende, «este tema es un desafío global que requiere un enfoque 'One Health'», que es un concepto, que literalmente significa 'Una salud' en inglés, en el que se conecta la salud humana, animal y ambiental.
«En la Región de Murcia, donde el agua es un recurso limitado y la reutilización es una práctica esencial, entender los riesgos y cómo mitigarlos es una prioridad tanto científica como social». En ello están investigadores como los que, con apoyo de la Comunidad Autónoma, sacan adelante iniciativas como este proyecto Agrocare.
-
Liderazgo de la Región en un área que anticipa nuevos riesgos en seguridad alimentaria
El proyecto de 'Producción agrícola sostenible y resiliente: mitigación del impacto del cambio climático en la transmisión de resistencias antimicrobianas en la producción y procesado de hortalizas de hoja', que es la denominación extensa de la iniciativa Agrocare, «sitúa a la Región de Murcia en una posición de liderazgo en investigación sobre resistencias antimicrobianas y sostenibilidad agrícola». Lo afirma su investigadora principal, la doctora Ana Allende, y lo justifica al apuntar con sus resultados «no solo aportarán conocimiento científico, sino que contribuirán a mejorar la resiliencia del sector hortícola, garantizando alimentos seguros, sostenibles y de alta calidad en un contexto de cambio climático». Se trata de un tipo de investigaciones que resultan «esenciales para anticipar riesgos emergentes y reforzar la seguridad alimentaria de manera preventiva y basada en evidencias», sintetiza.
En este caso, el proyecto está liderado por el grupo de Microbiología y Calidad de Frutas y Hortalizas del Cebas-CSIC, con el que colabora el grupo de Ingeniería del Frío y de la Seguridad Alimentaria de la UPCT, y que han logrado avanzar en lo que su líder califica de línea de investigación emergente a nivel internacional, «aunque todavía muy poco desarrollada en el contexto de la agricultura mediterránea».
El mismo equipo de investigadores lidera varios proyectos complementarios, como el denominado Recwater, del Ministerio de Ciencia e Innovación, y el Waterresist, de la autoridad Europea de Seguridad Alimentaria, (EFSA), que estudian la relación entre el uso del agua y la diseminación de resistencias antimicrobianas. En el caso que nos ocupa, explica Ana Allende, se incluye el desarrollo de modelos predictivos basados en inteligencia artificial, que resulta «una aproximación que no se había hecho hasta el momento». Gracias a este avance, detalla, «vamos a poder utilizar datos experimentales obtenidos en otros proyectos, así como desarrollar experimentos específicos que complementen los datos ya existentes».